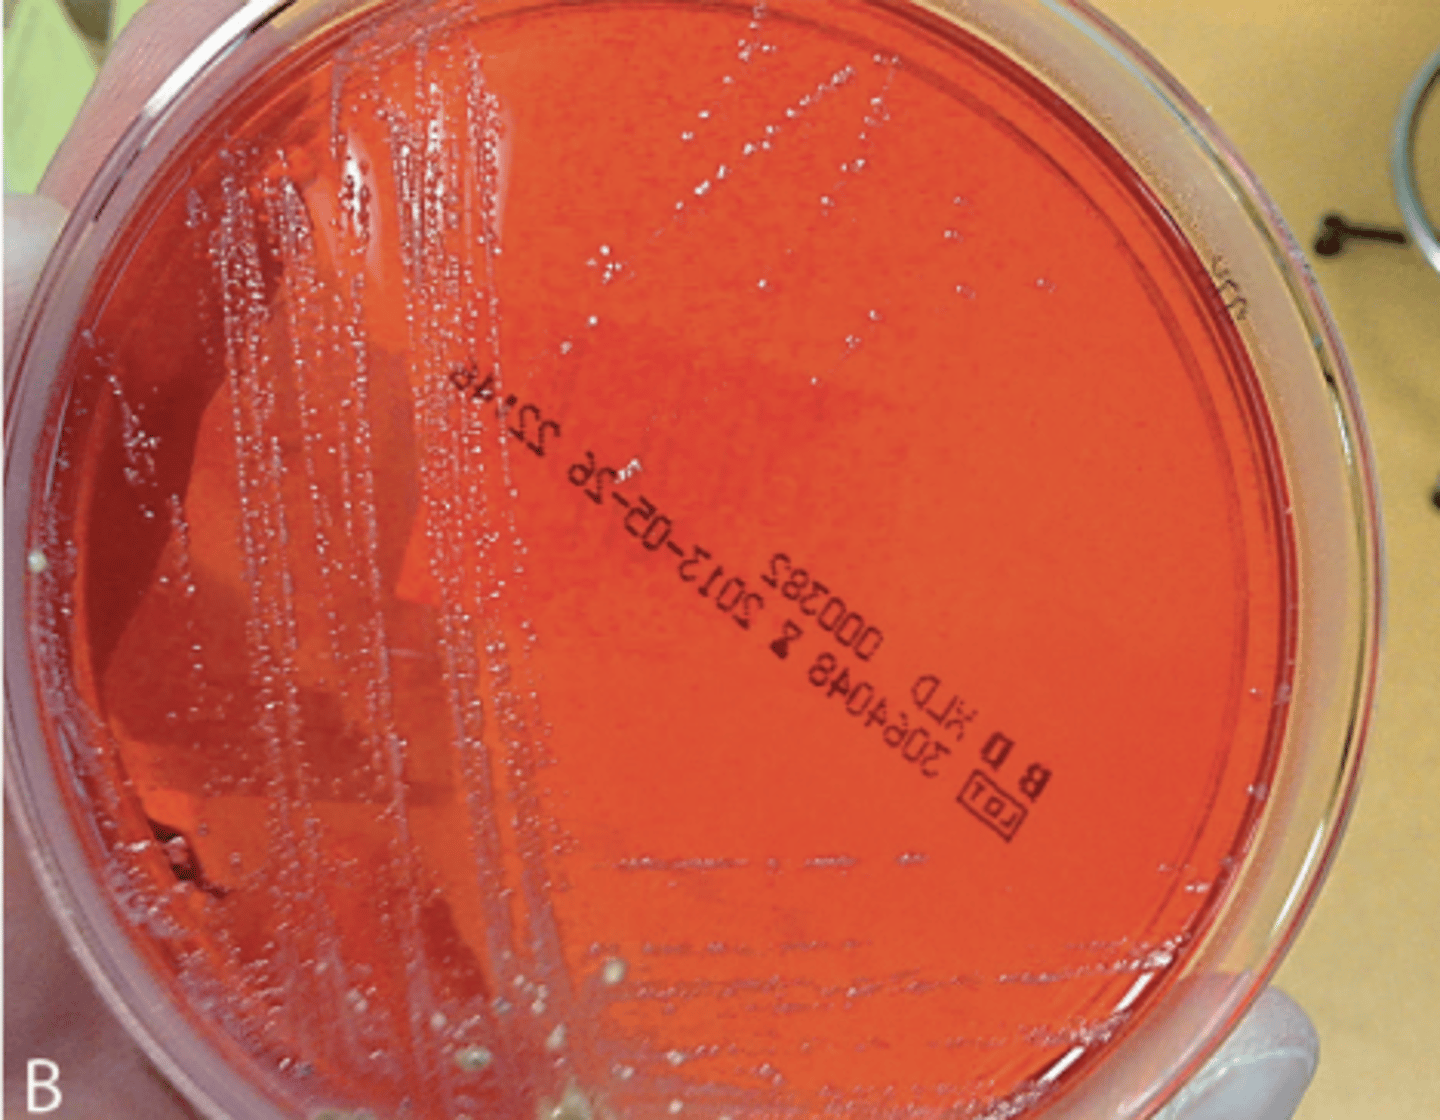
<p>Milieu : SS</p><p>Respiratoire : AAF</p><p>Température : 37 degrés</p><p>Délai : 24h</p><p>Aspect : Colonies de 2-3mm, rondes, à bords réguliers, brillantes </p>

1/16
Looks like no tags are added yet.
Name | Mastery | Learn | Test | Matching | Spaced | Call with Kai |
|---|
No analytics yet
Send a link to your students to track their progress
Quelle est la morphologie de la bactérie?
Bacille Gram -
Immobile
Non capsulée
Non sporulée

Quels sont les caractères biochimiques de la bactérie?
ENTÉROBACTÉRIES :
Oxydase -
Nitrate réductase +
Glucose +
Lactose -
H2S -
Quel est l'épidémiologie de la bactérie?
Endémique : Région tropicale
Espèces les + rencontrés : S.Dysenteriae ou flexneri
France : rare, 1% des infections intestinales
+++++ S.Sonnei > flexneri >>>>>>> Boydi > Dysenteriae
2 pics d'incidence :
0-9 ans et 20-49 ans

De quels infections est-il responsable?
Infection du tube digestif :
Syndrome de gastro-entérite : la + fréquente Syndrome dysentérique : étreinte, ténesme, selles glairo-sanglante...
SHU : très proche morphologiquement d'E.Coli
TIAC
Donner les facteurs de virulence
Endotoxine : LPS
Entérotoxine / Shigatoxine : responsable de SHU
Protéine IPA : invasion des macrophages
Quel est le mode de contamination?
Voie digestive féco-orale lié au péril fécal
Direct : interhumaine, manuportée
Indirect : Eau et aliments souillés
Donner les conditions de culture
Milieu : SS
Respiratoire : AAF
Température : 37 degrés
Délai : 24h
Aspect : Colonies de 2-3mm, rondes, à bords réguliers, brillantes
Quel est le réservoir de la bactérie?
Pathogène strict
Réservoir : Homme
Quel est le mécanisme physiopathologique?
1. Pénétration des cellules M
2. Phagocytose par les macrophages
3. Multiplication dans les cellules
4. Inflammation : destruction tissulaire
5. S.Dysenteriae : sécrétion de shigatoxine : SHU
Quelle est la dose infectieuse?
Faible
10 à 100 bactéries
Quel est le temps d'incubation?
1 à 4 jours
Quelles sont les complications possibles?
Déshydratation
Perforation colique
Occlusion intestinale (enfant+++)
Quels sont les facteurs de risque?
Voyage en zone d'endémie
Nourrissons
Personnes âgées
Immunodéprimés
Comment est réalisé le diagnostic?
Culture : Coproculture
Identification : Spectrométrie de masse MALDI-TOF
Agglutination
Recherche gène stx
PCR multiplex
Antibiogramme
Quel est le traitement d'une shigellose avec diarrhées sévères (>6x/j) ?
Réhydratation par voie orale
Correction des tb hydro-électriques
ATB : Azithromycine QSP 1 à 3 jours
ou Ciprofloxacine

Quel est le traitement d'une shigellose avec diarrhée bénigne/modérée? <6 selles/j
Réhydratation par voie orale
Correction des tb hydro-électriques
PAS d'ATB
Quels sont les moyens prophylactiques?
Hygiène des mains
Désinfection de l'eau
Nettoyage des fruits/légumes
Lutte contre le péril fécal
DÉCLARATION OBLIGATOIRE TIAC/Dysentérie